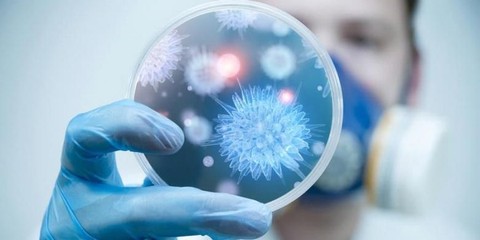

Waspadai Kanker Serviks,. Setiap 1 Jam ada 1 Wanita yang Meninggal di indonesia!

Pengertian Kanker Serviks
Kanker serviks atau kanker leher rahim adalah penyakit yang disebabkan akibat pertumbuhan jaringan sel rahim yang tidak normal yang kemudian berubah menjadi ganas. Sel kanker ini dapat berkembang dan menyebar ke jaringan tubuh lain dan bahkan bisa menyebabkan kematian.
Semua perempuan berisiko menderita kanker serviks, dari mulai remaja hingga wanita lanjut usia. Namun, kanker serviks ini cenderung menyerang wanita yang sudah aktif secara seksual. Di Indonesia sendiri sayangnya para wanita cenderung merasa tabu untuk sharing mengenai hal yang berhubungan dengan masalah seksual dan enggan untuk memeriksakan kondisi mereka ke dokter ahli. Oleh karena itu, biasanya kasus kanker serviks yang ditangani dokter kebanyakan sudah masuk stadium akhir/kondisinya sudah parah.
Jangan pernah malu untuk melakukan konsultasi pada dokter kandungan untuk mengetahui kondisi kesehatan rahim kamu. Meskipun belum menikah, bukan berarti kamu tidak diizinkan untuk berkonsultasi karena kanker serviks bisa menyerang siapa saja. Bahkan, WHO menyatakan pada tahun 2012 usia dari penderita kanker serviks kebanyakan berumur dibawah 20 tahun (sumber : https://www.alodokter.com/kanker-serviks)
 Foto: https://www.alodokter.com/kanker-serviks
Foto: https://www.alodokter.com/kanker-serviks "Pada tahun 2014, WHO menyatakan adanya 9.476 kasus kematian akibat kanker serviks. Sedangkan jumlah kasus baru kanker serviks yang ditangani berjumlah hampir 21 ribu".https://www.alodokter.com/kanker-serviks |
Virus Human Papillomavirus: Penyebab Utama Kanker Serviks
Tahukah kamu? Hampir semua kasus kanker serviks disebabkan oleh virus human papillomavirus (HPV). Virus ini merupakan kumpulan berbagai jenis virus penyebab kutil (tangan, kaki & alat kelamin). Ada 2 jenis virus HPV yang dapat menyebabkan kanker serviks pada wanita, yaitu HPV-16 & HPV-18.
Infeksi virus HPV dapat terjadi jika kita bersentuhan langsung dengan pengidap atau benda yang sudah terkontaminasi dengan HPV-16 & HPV-18. Dalam tahap awal infeksi, HPV ini hampir tidak ditemukan gejala sehingga bisa saja orang yang mengidap kanker serviks tidak menyadarinya.
 Foto: https://www.msd-indonesia.com/Indonesian/Pages/HPV.aspx
Foto: https://www.msd-indonesia.com/Indonesian/Pages/HPV.aspx
Faktor Terjadinya Penularan Papillomavirus
Seperti yang sudah dijelaskan, infeksi HPV penyebab kanker serviks bisa terjadi saat kita bersentuhan langsung dengan kulit/area dimana terdapat HPV maupun dengan benda yang sudah terkontaminasi dengan virus HPV-16 & HPV-18.
Berikut ini adalah beberapa hal yang bisa menyebabkan terjadinya penularan virus HPV-16 & HP-18 penyebab kanker serviks:
- Berganti - ganti pasangan seksual akan meningkatkan risiko terinfeksi HPV
- Sistem kekebalan tubuh yang lemah memungkinkan mudahnya virus HPV untuk menginfeksi sel tubuh
- Memiliki banyak anak. Makin banyak anak yang dilahirkan maka akan menggandakan risiko infeksi kanker serviks karena perubahan hormon pada wanita hamil membuat rahim lebih rentan terserang HPV
- Berbagi barang pribadi dengan orang lain. Misalnya handuk & pakaian dalam
- Wanita yang merokok berisiko 2x lipat menderita kanker serviks
- Tidak menjaga kebersihan. Cuci tangan & mandi dapat mengurangi risiko penularan virus
- Menggunakan toilet umum tanpa dibersihkan dengan antiseptik dulu
- Aktivitas seksual terlalu dini
Foto: https://health.kompas.com/read/2013/06/27/1433328/Penyakit.dengan.Penularan.Paling.Cepat
Foto: https://health.kompas.com/read/2013/06/27/1433328/Penyakit.dengan.Penularan.Paling.Cepat
Deteksi Dini Kanker Serviks
Gejala kanker serviks pada stadium awal sering kali tidak dirasakan oleh pengidapnya, sehingga dibutuhkan screening untuk mendeteksi adanya kelainan dalam rahim. Pengobatan dalam tahap pra kanker/ stadium awal akan memberikan harapan hidup lebih besar daripada sudah parah.
Deteksi dini yang dilakukan adalah dengan melakukan prosedur pap smear. Prosedur ini berguna untuk mendeteksi adanya sel-sel abnormal yang berpotensi menjadi sel kanker. Pap smear dapat dilakukan hanya kepada wanita yang sudah berhubungan seksual. Berikut ini adalah tahapan dalam melakukan pap smear:
- Kamu akan duduk di meja pemeriksaan dengan posisi kaki membuka lebar (tanpa mengenakan celana & celana dalam).
- Pengecekan bagian luar vagina apakah dalam keadaan normal atau tidak.
- Membuka vagina dengan speculum yang dapat mempermudah dokter untuk mengambil sampel jaringan leher rahim kamu. Proses memasukan speculum tidak menyakitkan tetapi hanya memberikan sedikit rasa mengganjal.
- Pengambilan sampel jaringan di luar mulut rahim dengan spatula.
- Pengambilan sampel jaringan di saluran hingga bagian dalam rahim dengan sikat kecil (cytobrush).
- Jika proses pengambilan sample sudah selesai, kemudian sampel akan dikirim ke laboratorium untuk diperiksa .
 Foto: https://faktakanker.com/kanker-serviks/pap-smear-tahapan-proses-dan-manfaatnya
Foto: https://faktakanker.com/kanker-serviks/pap-smear-tahapan-proses-dan-manfaatnya
| Baca Juga : #FORUM Gimana Proses Pemakaian Behel? Sakit gak? |
Vaksin Kanker Serviks
Tapi, kamu tidak perlu takut dengan kanker serviks ini. Dengan kecanggihan dunia medis saat ini, vaksin untuk mencegah infeksi virus HPV pun sudah tersedia. Vaksin yang tersedia saat ini diantaranya adalah
- Vaksin bivalen untuk 2 jenis HPV yaitu : HPV-16 & HPV-18
- Vaksin kuadrivalen untuk 4 jenis yaitu : HPV-6,11,16 & 18
- Vaksin nonavalen untuk 9 jenis yaitu : HPV-6,11,16,18, 31,33,45 & 58
Kapan Perempuan harus di vaksin HPV?
Vaksin sebagai pencegahan terhadap virus HPV diberikan sebanyak 3 dosis dalam 3 kali pemakaian pertama kali pada masa remaja berusia 11-12 tahun. Lalu, vaksin kedua akan diberikan 2 bulan setelah vaksin pertama, dan kemudian vaksin ketiga menyusul setelah 6 bulan dari vaksin pertama.
Untuk ibu yang memiliki putri, disarankan untuk berkonsultasi dengan dokter ahli untuk penjadwalan dan pemilihan jenis vaksin yang tepat. Selain perempuan, pemberian vaksi kepada pria juga perlu dilakukan untuk menghindari kutil kelamin, kanker anus dan ternggorokan. Biasanya pemberian vaksin HPV pada pria direkomendasikan kepada pria yang berusia 26 tahun atau memiliki gangguan imunitas atau pria yang aktif berhubungan intim dengan sesama pria.
 Foto: https://m.prodia.co.id/InfoKesehatan/ArtikelKesehatanDetails/kapan-vaksin-hpv-diperlukan
Foto: https://m.prodia.co.id/InfoKesehatan/ArtikelKesehatanDetails/kapan-vaksin-hpv-diperlukan



